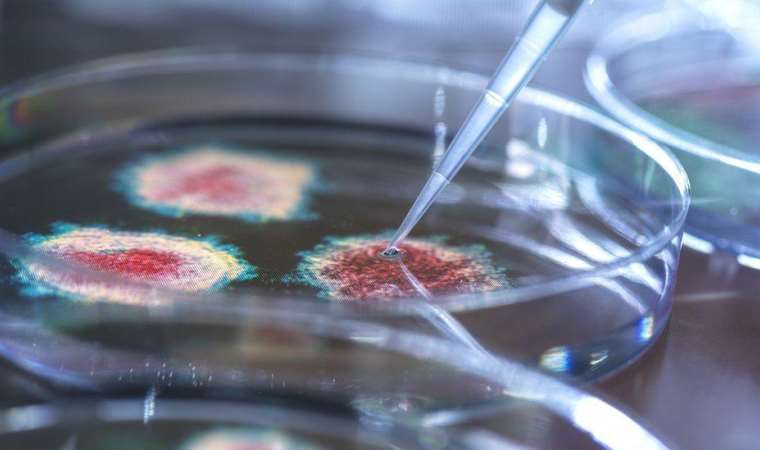

Facebook ve Telegram'da "mikrop inkarcılığı" gruplarının 10 binlerce üyesi var. Üyelerin bazıları virüslerin var olmadığına, bazıları da mikropların var olduğuna ancak hastalıklara neden olmadığına inanıyor.
"Uzun yıllar boyunca alternatif tıpla ilgilendim. Daha sonra koronavirüs ile birlikte ilgim yeni bir seviyeye çıktı."
Sözler Güney Afrika'nın Cape Town kentinde bir natüropati uzmanı, yani doğal teknikleri uygulayan bir terapist olan Veronica Haupt'e ait.
Veronica'nın tanıdık bir hikayesi var. Önce sağlık konusuyla ilgiliydi ve alışılagelmişin dışındaki tedavi yöntemlerini okumaktan keyif alıyordu. Ardından Covid-19 aşısının içeriğinden ve bazı iş yerlerinin aşıyı zorunlu tutmasından şüphe etmeye başladı.
Hikayesinin sağlık konusuna ilgi duyan birçok kişininkinden ayrıştığı bölüm de böyle başlıyor.
"Bence insandan insana geçtiği söylenen bütün bir bulaşıcı hastalık fikri kesinlikle çok uzun zamandır insanlığa anlatılan bir masal" diyor.
Veronica, kendisi gibi mikropların var olduğuna inanmayan insanların olduğu çevrim içi bir grubun üyesi. Aksi bilimsel kanıtlara rağmen grup gün geçtikçe büyüyor.
Sosyal medyada yapılan bir analiz "mikrop inkarcıları"nın İngilizce karşılığı olan germ deniers anahtar kelimesi arandığında, bu konunun 2020'den önce neredeyse hiç konuşulmadığını, Covid-19 pandemisiyle gündeme geldiğini gösteriyor.
Ancak konu pandeminin sonra ermesiyle rafa kalkmadı. Aksine sürekli artan miktarda bahse konu oldu ve anahtar kelime kullanımı 2023'te son üç yılın toplamını geçti.
Facebook ve Telegram'da on binlerce üyesi olan mikrop inkarcılığı grupları var. Bazıları virüslerin var olmadığına, bazıları da mikropların var olduğuna ancak hastalıklara neden olmadığına inanıyor.
İnkarcıların birçoğu inançlarını 1800'lerde ortaya atılmış ancak geçersizliği kanıtlanmış bir teoriye dayandırıyor.
O dönemde mikropların hastalıklara sebep olduğu kanıtlanmış olsa da, Fransız bilim insanı Antoine Bechamp'ın arazi teorisini ortaya atması, mikroplar ve hastalıklar arasındaki ilişkinin sorgulanmasına neden oldu. Teoriye göre mikroplar sadece sağlıksız bir bedene girdiğinde hastalığa sebep olan mutantlara dönüşen zararsız varlıklardı.
Bechamp'ın teorisi mikropların hastalıklara sebep olduğunu gösteren sayısız kanıtın ortaya atılmasıyla çürütüldü.
Mikrop inkarcılığının 19. yüzyıldan kalma bir teoriye bağlılıktan çok, ana akım herhangi bir şeyin tamamen reddedilmesiyle ilgisi var gibi görünüyor.
Hükümetler ya da sağlık kurumlarından bir açıklama geldiğinde, bunun sorgusuz sualsiz yanlış olduğuna dair yayılan bir inanç var.
Bu, hükümetleri sorgulamanın yanlış olduğu anlamına gelmiyor.
YouTube'da eğitici içerikler yayımlayan Moleküler Biyolog Dr. Dan Wilson, bu bilim dışı iddiaların geniş tanımıyla "sağlık" başlığı altında yer aldığını söylüyor.
'Biyolojinin düz dünyacıları'

Bu tanım diyet, egzersiz ve diğer pratiklerle fiziksel ve psikolojik olarak iyi olma hali arayışını da kapsıyor.
Bu arayıştakiler "doğal olmadığı için" genellikle ilaç kullanmama eğilimindeler. Bu eğilimi destekleyen milyonlarca sosyal medya paylaşımı var.
Dr. Wilson, bu arayışın insanlara hakimiyet duygusu verdiğine dikkat çekiyor. Ne tükettiğinizi değiştirerek, sadece hastalıklardan korunduğunuza değil, aynı zamanda hayatınızı en iyi şekilde yaşayabildiğinize inandırıyor; "Mikrop inkarcılığına kadar gitmesi gerekmiyor. Sadece bazı vitaminlerin ya da belirli bir yaşam biçiminin hastalıkları engellediği fikri" diyor.
Bütün hastalıklar mikrop kaynaklı değil. Ancak Veronica, herhangi bir bilimsel dayanağı olmadan, bütün hastalıkların vücudumuza giren toksinlerden, kirlilikten ya da elektromanyetik dalgalardan kaynaklandığını düşünüyor.
Danışanlarına, "Sağlıklı olmak doktorunuzun değil, sizin elinizde" diyor.
"Biyolojinin düz dünyacıları"
Facebook'ta mikrop inkarcılığı gruplarının en büyüğünde üyelerin doktorlardan, ilaçlardan ve aşılardan nasıl korunacağına dair tavsiyeler de paylaşılıyor.
Grubun 2019'da 150 olan üye sayısı bugün 30 bini geçti.
Dr. Wilson, "Mikrop inkarcılığı ve aşı karşıtlığı grupları kesinlikle birçok kesişime sahip. Hatta mikrop inkarcılarının aşı karşıtı çemberin içinde yer aldığını söyleyebilirim" diyor ve ekliyor:
"Onlara biyolojinin düz dünyacıları diyorum çünkü onlara benzer şekilde Dünya'nın yuvarlak olduğunu gösteren fotoğrafları gördükleri halde bunu inkar etmeye devam ediyorlar.
"Virüsü bir hayvana bulaştırıp onu hasta edebiliriz. Aynı genetik dizilimi insanlarda da bulup kişiden kişiye nasıl bulaştığını takip edebilir ve hastalığın nasıl yayıldığını izleyebiliriz."
Virüsler ve diğer mikropların mikroskopta göründüğünü söyleyen Dr. Wilson şöyle devam ediyor:
"Ancak bu kanıt zenginliğine rağmen mikrop inkarcılığının farklı türleri kitleler arasında yayılıyor. Örneğin HIV'nin AIDS'e neden olmadığı fikri gittikçe yaygınlaşıyor ve ana akım bir komplo teorisi haline gelmesinden çekiniyorum".
2000'li yılların başında, Veronica'nın memleketi Güney Afrika'da, dönemin Devlet Başkanı Thabo Mbeki, AIDS'in HIV virüsünden kaynaklandığını reddetmişti.
Mbeki, virüsün vücutta çoğalmasını durduran hayat kurtarıcı antiretroviral ilaçların tedariğine de yanaşmamıştı.

Harvard Üniversitesi'nin yaptığı bir araştırmaya göre, bu tutumu 300 binden fazla ölümün önlenememesiyle sonuçlandı.
Güney Afrika'da HIV'in önlenmesi ve tedavisi konusunda sahada çalışan insanlar, bugünkü durumun 20 yıl öncesinden farksız olduğunu söylüyor.
AIDS inkarcılığı karşı karşıya oldukları en büyük sorun değil.
Ancak yavaş yavaş yükselen şüphe dalgası, Roberto Pereira gibi HIV araştırmacılarının ürpermesine neden oluyor:
"Bunun doğru olduğunu düşünmüyorum, özellikle de bu ülkede bu kadar çok acıya neden olmuşken. Gerçekten kanımı donduruyor" diyor ve ekliyor:
"Tarihin tekerrür ettiğini görmek istemezsiniz ama görünen o ki tarih sık sık tekerrür ediyor."